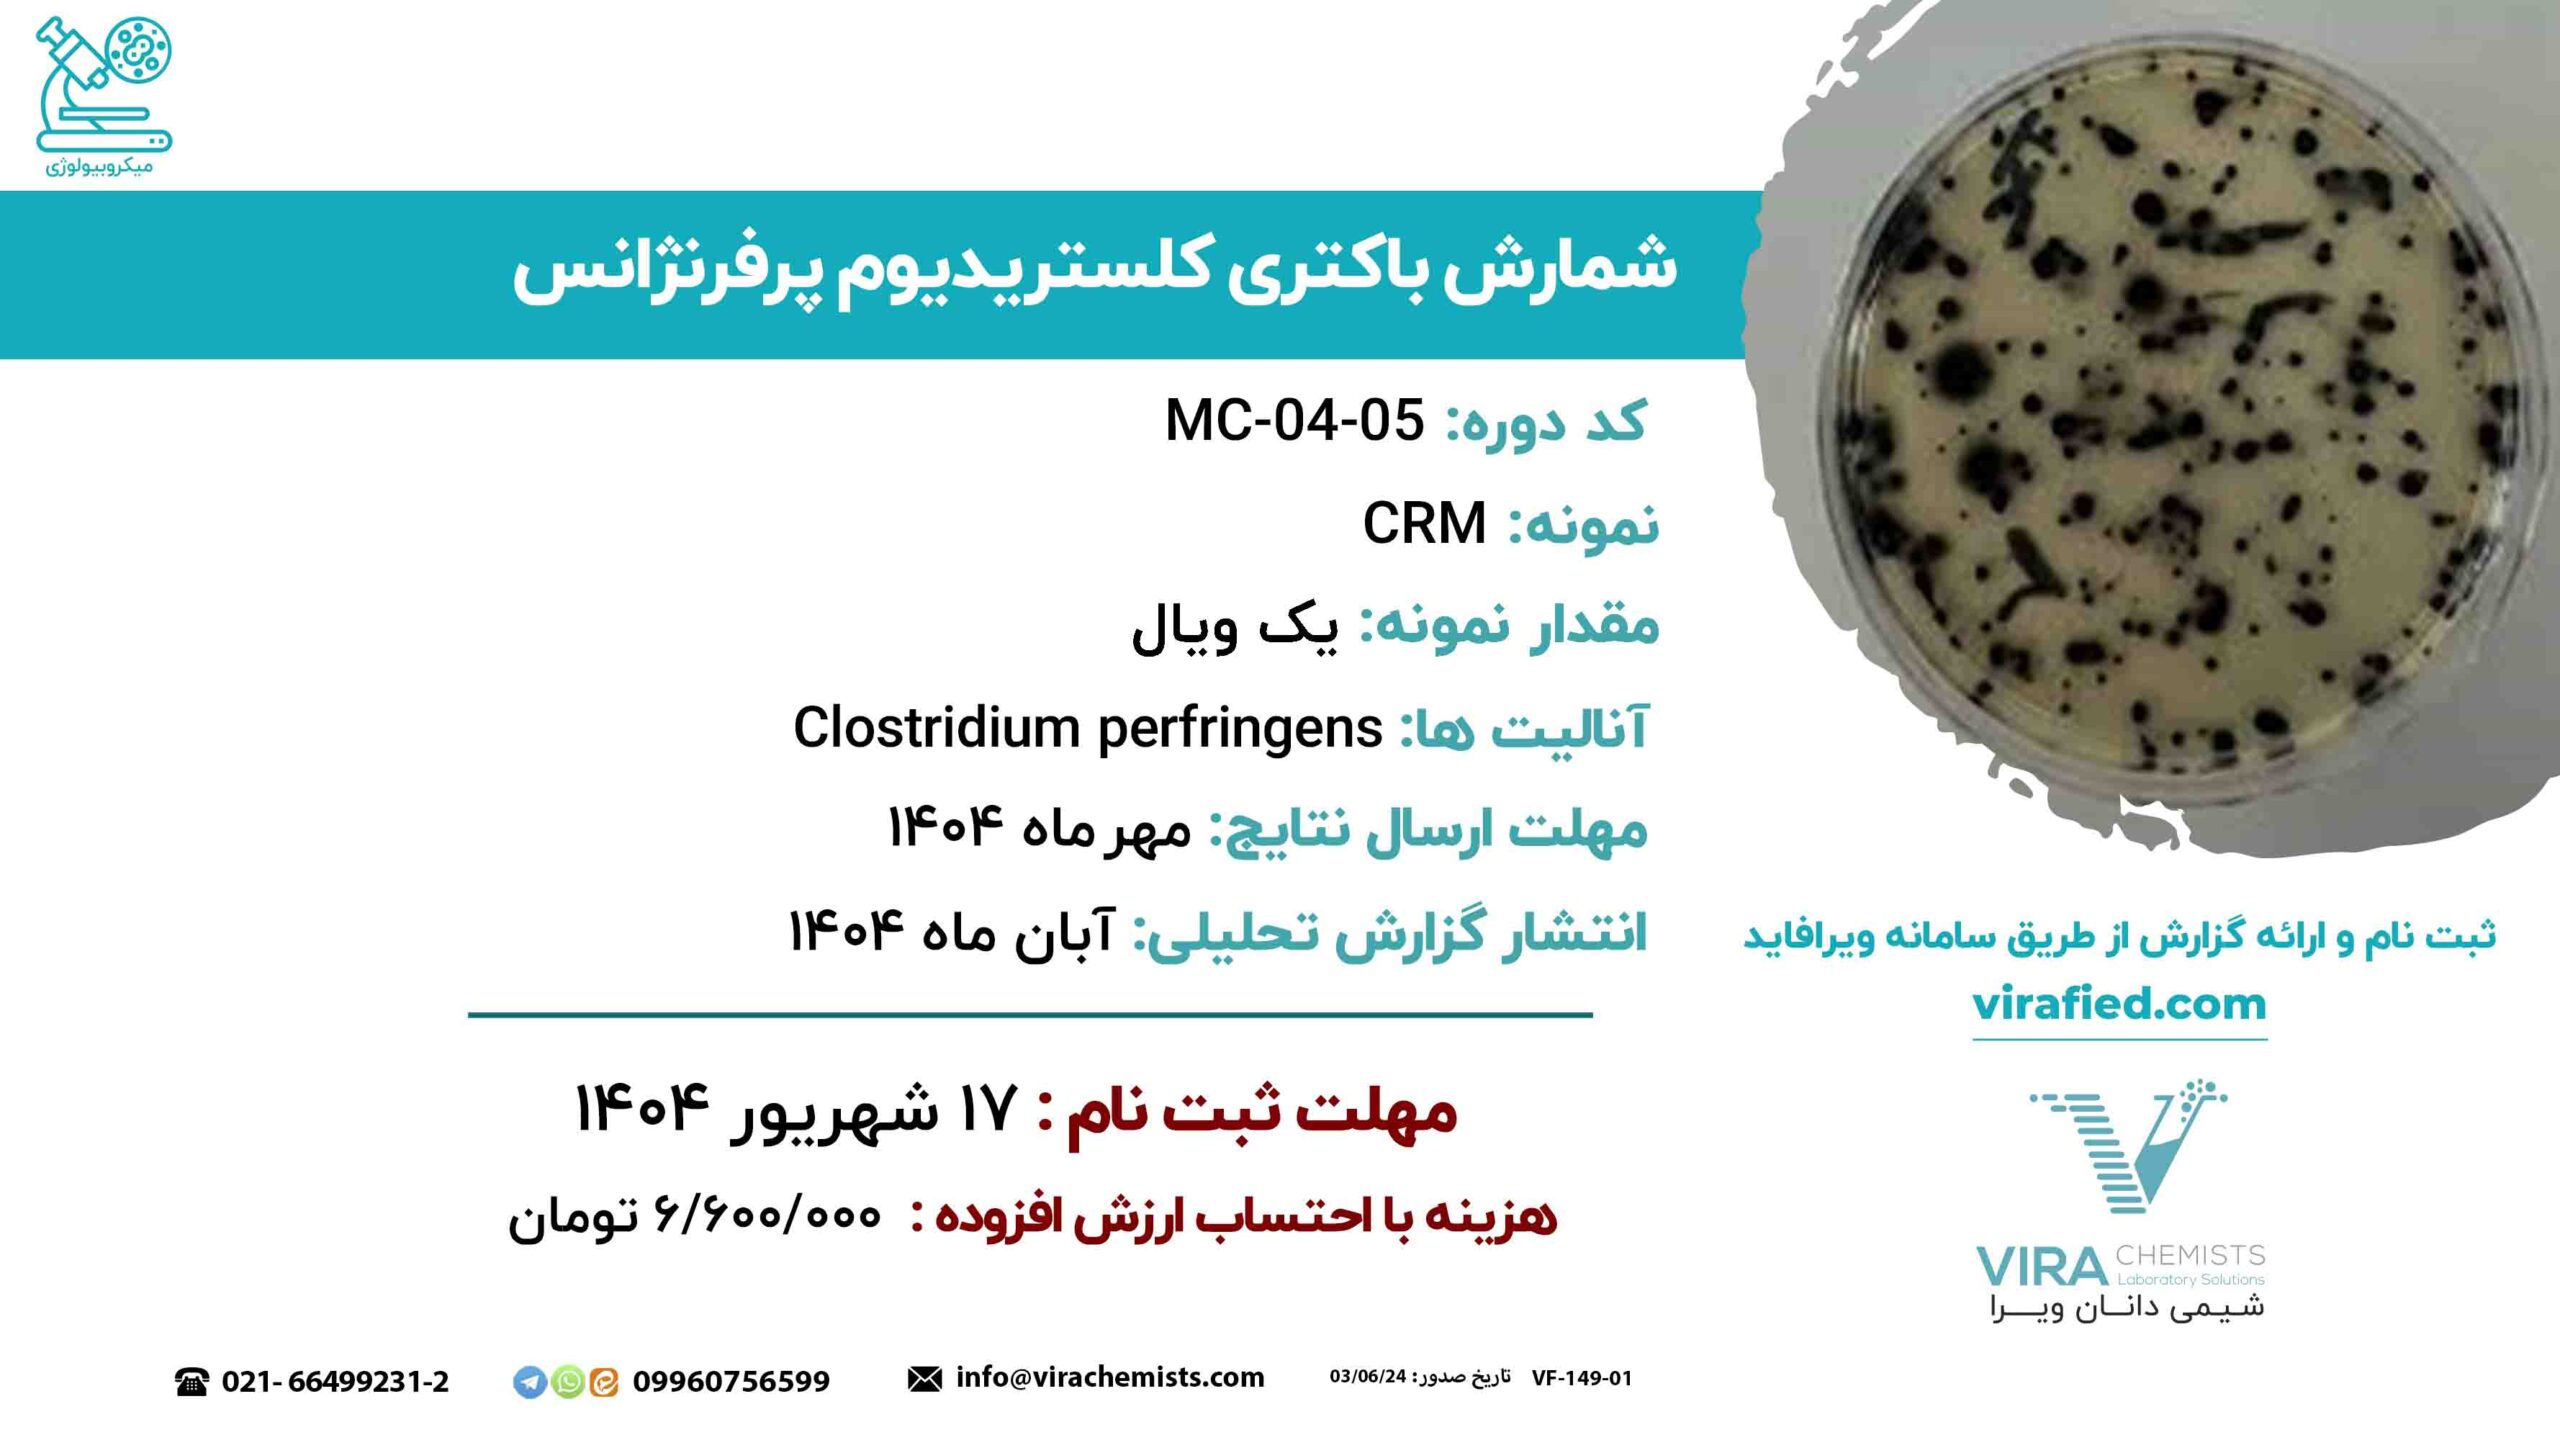
MC-04-05_790678

مزایای مشارکت آزمایشگاهها در برنامههای آزمون مهارت از دیدگاه ILAC
مشارکت در برنامههای آزمون مهارت (Proficiency Testing – PT) تنها یک الزام اعتباربخشی نیست، بلکه ابزاری کلیدی برای ارزیابی شایستگی فنی، مدیریت ریسک و بهبود مستمر عملکرد آزمایشگاهها است. طبق دیدگاه ILAC، آزمون مهارت از طریق مقایسه نتایج با مقادیر مرجع یا سایر آزمایشگاهها، امکان شناسایی خطاها، ارزیابی روشهای آزمون، و ارتقای کیفیت نتایج را فراهم میکند.
از مهمترین مزایای PT میتوان به تأیید صلاحیت فنی، بهبود فرآیندهای آزمایشگاهی، آموزش و توانمندسازی کارکنان، و جلب اعتماد نهادهای اعتباربخشی اشاره کرد. همچنین، نتایج این برنامهها در تعیین صحت و دقت روشها، توسعه مواد مرجع داخلی و مدیریت ریسک سازمانی نقش اساسی دارند.
در مجموع، آزمون مهارت ابزاری راهبردی برای حفظ اعتبار، ارتقای کیفیت و افزایش اعتماد به نتایج آزمایشگاهی به شمار میرود.